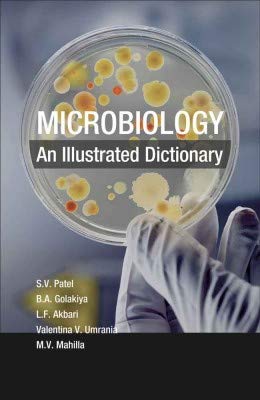
Microbiology: An Illustarted Dictionary

Microbiology: An Illustarted Dictionary
Brand: Buyy.in
Description
Sold by: Buyy.in
Customer Reviews (0)
No reviews yet. Be the first to review this product!
Product Information
Country of Origin
India
Manufacturer
buyy
Model Number
BUY-ST-MICROB-163
Return Policy
Returnable within 7 days
You can return this product within 7 days of delivery for a full refund if you're not satisfied.
Customer Reviews
No reviews yet
Be the first to review this product!
Questions & Answers
(0)Login to ask questions
No questions yet
Be the first to ask about this product!
Similar Products

HUMAN ANATOMY 6E
by Buyy.in

Ayurveda Samhita
by Buyy.in

Pride & Prejudice
by Buyy.in

CAPEX Incentives in India
by Buyy.in

OBJECTIVE AGRICULTURE 23rd ED. S.R.KANTWA
by Buyy.in

Tulip of Istanbul (P.B)
by Buyy.in